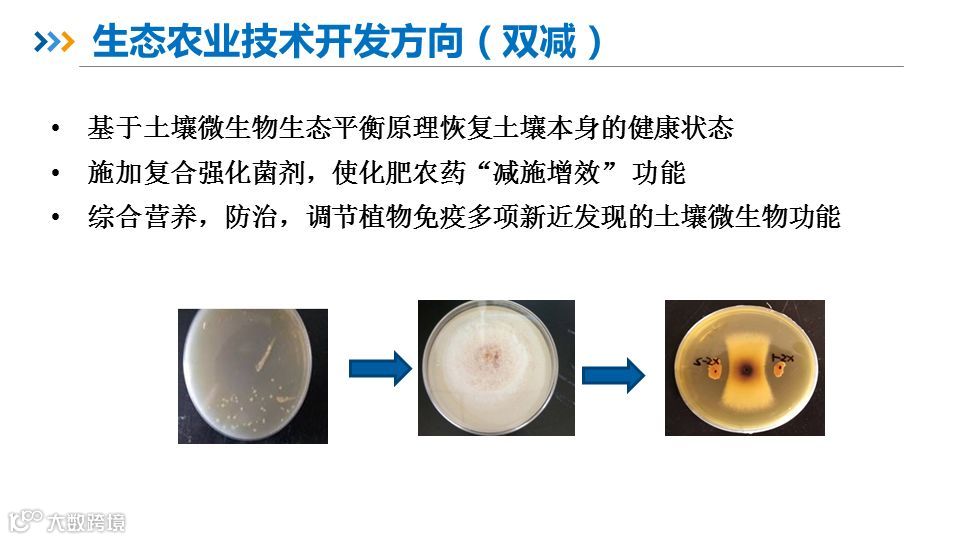
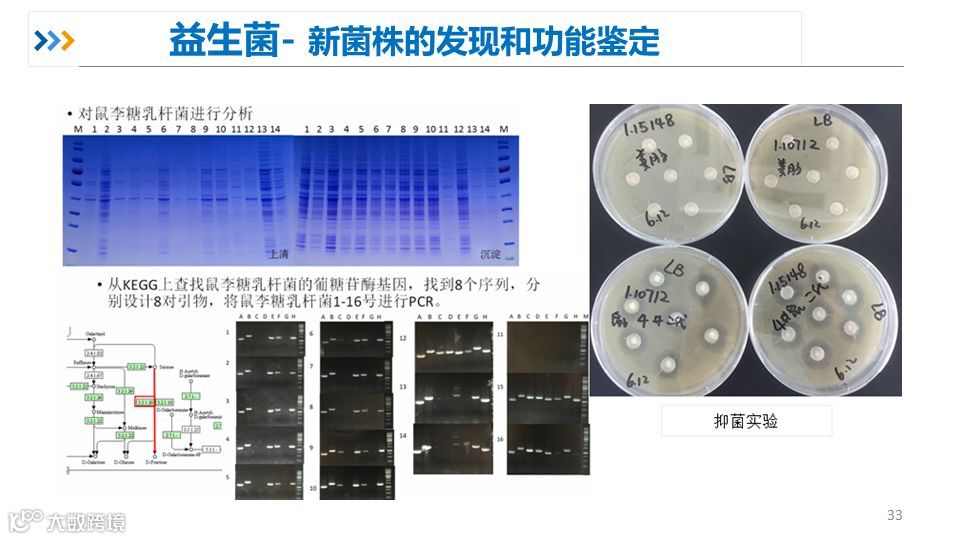

2019科技成果直通车(京津冀站)
活动简介
“科技成果直通车”是由科技部火炬中心发起的,旨在加速科技成果与产业资源精准对接的系列路演和对接交流活动。自2016年活动开展以来,受到产、学、研、资、用各方的高度关注和广泛欢迎,逐渐形成项目精、受众优、规格高的品牌优势。
科技成果直通车(京津冀站)第三场活动,“医疗健康领域项目路演”活动于9月10日在北京市房山区中粮健康科技园成功收官,来自医疗健康领域的8个项目参加了路演,今天为大家介绍的是中科院微生物所技术转移中心的全链条生物技术开发科技服务平台项目。

路演视频
项目简介
全链条生物技术开发科技服务平台项目——中科院微生物研究所技术转移转化中心
中科院微生物研究所技术转移转化中心是科技部批准的国家级技术转移示范机构。中心围绕生物产业共性技术,通过成果的中试放大与产业衔接,致力于将科研成果转化为实际生产力,提升生物产业的创新能力和竞争力。中心按照技术产业化的规律,配备有跨学科专业的研发队伍及经验丰富的工程技术人员,包括10余位博士,并拥有现代化的仪器设备,可以满足绝大多数生物产业项目的产业化技术开发和工艺放大。中心目前研发的项目集中在生物智造,大健康,生态农业和环境工程四个领域。
1
微生物所概况



2
技术转移转化中心介绍







3
中心部分项目介绍

生物智造

生态农业

环境工程



健康产业

如对以上项目感兴趣可以后台留下联系方式,相关工作人员会和您联系。
中技所将持续为路演项目和其他成果转化项目提供专业的供需对接和转化落地服务。未来,中技所将通过常态化的科技项目路演活动,为更多的项目团队、科技企业和投资机构提供更专业的服务。
更多项目路演视频可以通过登陆注册燧石星火直播平台进行观看。
网站地址:
https://www.chinahtz.com/index.do
精彩回顾
直通车路演项目 | 一类新药ACT001开发项目
直通车路演项目 | HB-CA01用于抗菌感染治疗的新药研发项目
2019科技成果直通车 (京津冀站)医疗健康领域项目路演成功收官



